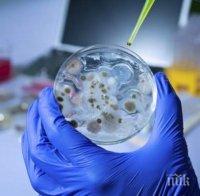
Заразата от антракс във Варненско е овладяна

Жителите на Млада гвардия минаха на зеленчукова диета заради антракса

ПИК с нов канал в Телеграм
Последвайте ни в Google News Showcase
Жителите на поразеното от антракс с. Млада гвардия минават на зеленчукова диета. "И без това е горещо, ще хапваме боб и тиквички, докато добитъкът е в карантина", обясни кметицата Катя Тодорова.
Привечер там започна имунизацията против антракс на 600 крави, овце, кози, магарета и коне, а във вторник на общоселско събрание ветеринари ще разяснят на фермерите мерките за предпазване от болестта.


"Ще бием на животните жива ваксина, която осигурява имунитет след седмица. През това време те ще са под ключ, а млякото им ще се изхвърля. Гражданска защита ще осигури водоноски и храна за добичетата по заявка. Ще направим и пълна инвентаризация на животните. Ако открием такива без марки, ще има актове за стопаните им", обясни шефът на Българската агенция за безопасност на храните /БАБХ/ д-р Дамян Илиев. Той уточни, че БАБХ и полицията разследват действията на частната ветеринарка д-р Пенка Велкова и семейството на умрелия от анткракс стопанин на заразената крава Румен Янков. Той бе погребан в понеделник.
На метри от дома му полиция бдеше край обора на 66-годишния Марин Кръстев, чиято юница умря в неделя следобед. И тя се хранела на селското пасище, откъдето се предполага, че е тръгнала заразата. Все още не е ясно дали 500-килограмовата бременна крава е била поразена от антракс, но преди пробите да излязат, тя ще бъде заровена в дълбок трап и полята със сода каустик, разясни шефът на БАБХ. Според него има риск да се разболеят още животни.
За транжиралите и ялите заразено месо обаче засега няма опасност, показаха резултатите от изследванията на 22 души. От РЗИ уточниха, че чакат пробите на още четирима. "Листата на контактните непрекъснато расте, сред тях е и екип на Спешна помощ, прегледал починалия Румен. Нито един няма оплаквания, на всички е предписана терапия", каза зам.-министърът на здравеопазването д-р Ваньо Шарков след заседание на областните кризисен щаб. Не него бе задействан план за действия при епидемия в общините Варна, Провадия, Ветрино и Девня, където е било разнесено месото от антраксната крава.
Торището край Млада гвардия, където бяха намерени карантиите й, вече е дезинфекцирано. Поради липса на средства от 2 г. то нямало охрана, призна кметицата. "Няма читав контрол като при Тато, затова стана белята. Ваксините все не стигат, а и докторите си гледат работата през пръсти", обобщиха неколцина пенсионерки от Млада гвардия.




































